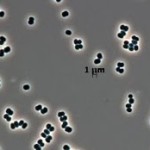

מחקר חדש מגלה שוני גנטי מפתיע בין תאי העצב במוח

בעבר סברו המדענים שכל תא בגוף האדם מכיל את אותו ה-DNA, כאשר החלקים שיבוטאו ממנו תלויים בסוג התא ובתפקידו, אך לאחרונה מחקר בינלאומי אשר הובל על-ידי חוקרים ממכון סאלק בקליפורניה, בראשותו של פרופ’ מייק מקונל, מצא שהגנום אשר נמצא בתוך כל תא עצב שונה מתא לתא במידה גדולה ממה שחשבו עד כה. במחקר בודדו החוקרים… המשך הקריאה